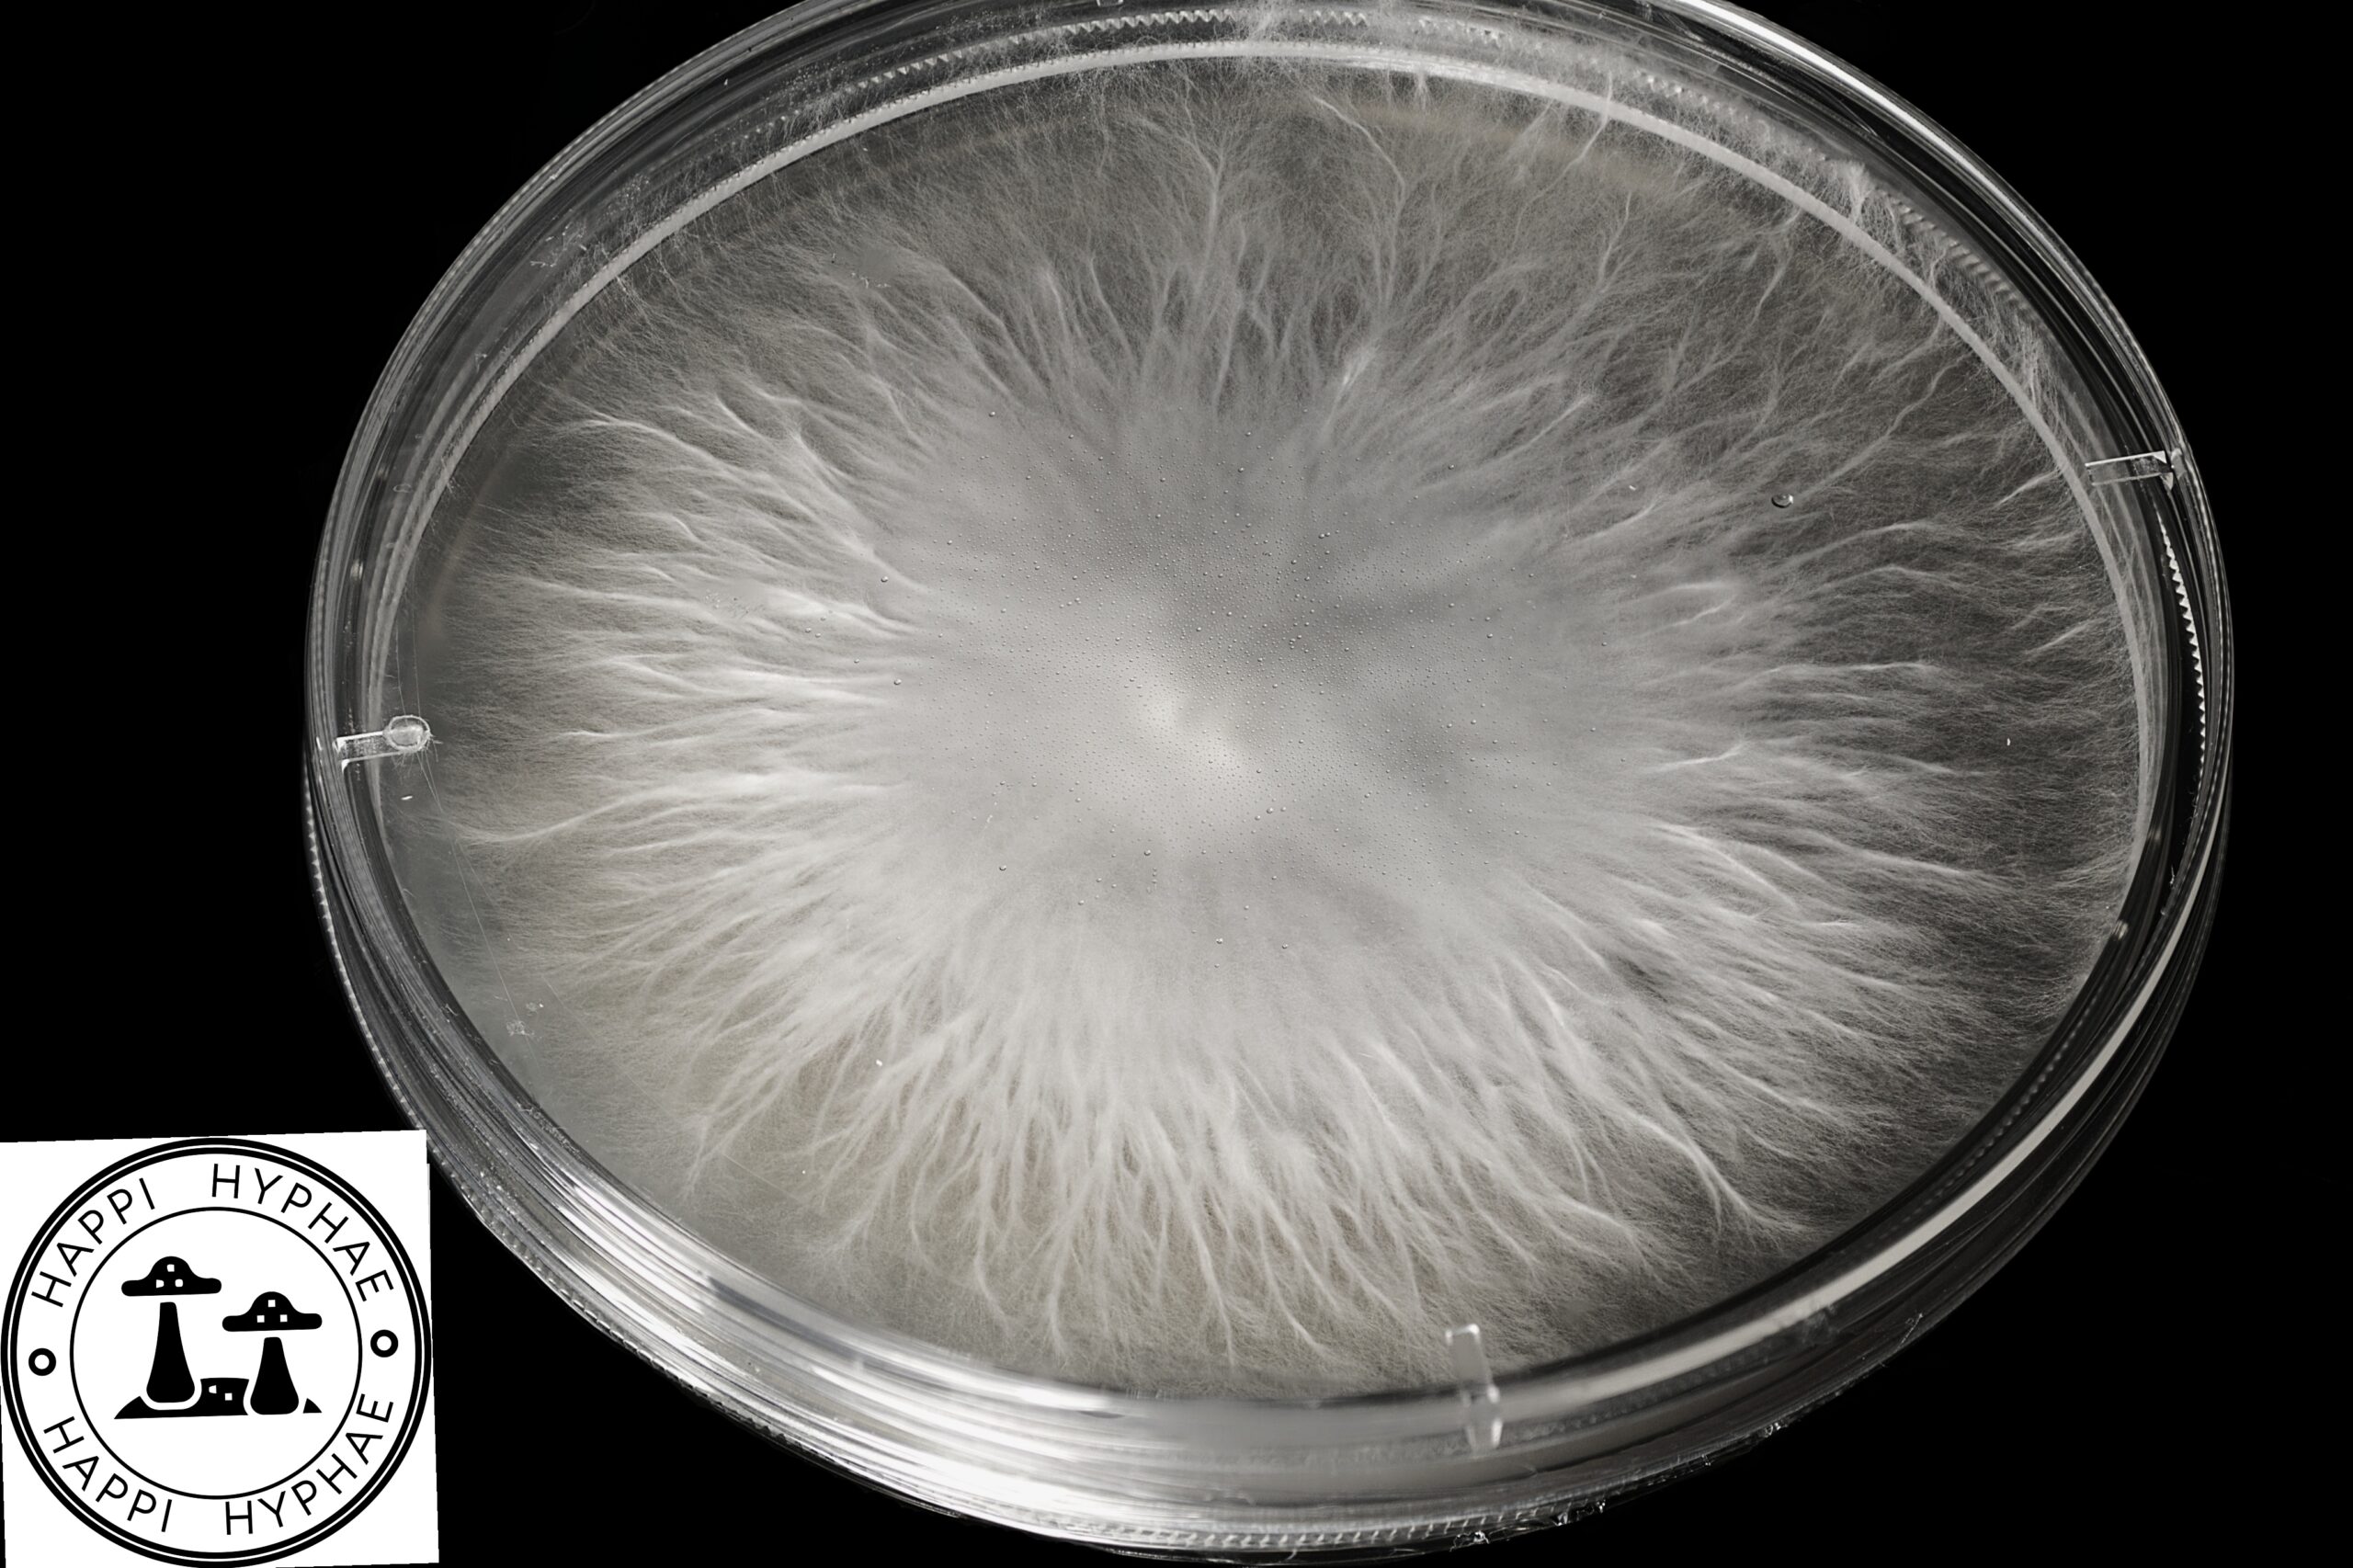
Blue Nips Research Plate

Happi Hyphae
Sale!
Actives, Cultures
Blue Nips Research Plate
Original price was: $30.00.$25.00Current price is: $25.00.
This is a Shakti isolate by Buster Drey. This is my all time favorite cube culture. Everyone should have this in their collection! The photos don’t do justice on the color of these things!
MICROSCOPY USE ONLY!!!
Units Sold: 1
Terms and Conditions
Many orders of our research cultures Tubes and plates are made once the order is received and require additional time to prepare and ensure the quality of the product. Expect at least a week on research plates. With tubes it varies. Some cultures will have varying growth patterns, as well as the genetic differences for cultures. For research purposes only. All products are produced in a sterile setting.
Shipping costs
| Shipping from | United States (US) |
| Within United States (US) | $6.00 |
National Shipping Details
| Minimum shipping charge per order | $6.00 |
| Maximum shipping charge per order | $6.00 |